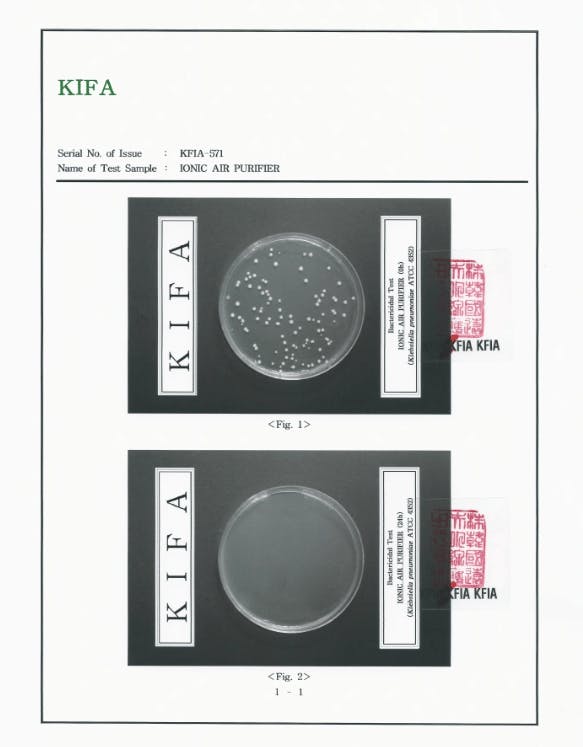

皆様少しずつですが暖かい季節が近づいております。皆様のキッチン周りも冬とは違いコバエ、カビなどで大変な季節になりますね。イオニスプラグは強力な空気中のカビ菌除去力を発揮し夏場高温高湿の環境に漏出されている、果物、カレーなどに生えやすいカビ菌を防いでくれます。さらに流し周りの様々な匂いも同時に除去することによりコバエなどの有害昆虫にも非常に効果的です。家族の食卓の関門であるキッチンイオニスプラグで綺麗にしませんか?
製品公式ホームページ
https://ionicjp2022.wordpress.com/
*添付のGIFの映像は製品の効果を理解させるためのイメージあり実際の映像ではございませんのでご注意お願い致します。
※ 大気中の肺炎菌培養後、殺菌力の試験成績書です。(韓国公認試験場KIFA検査成績)